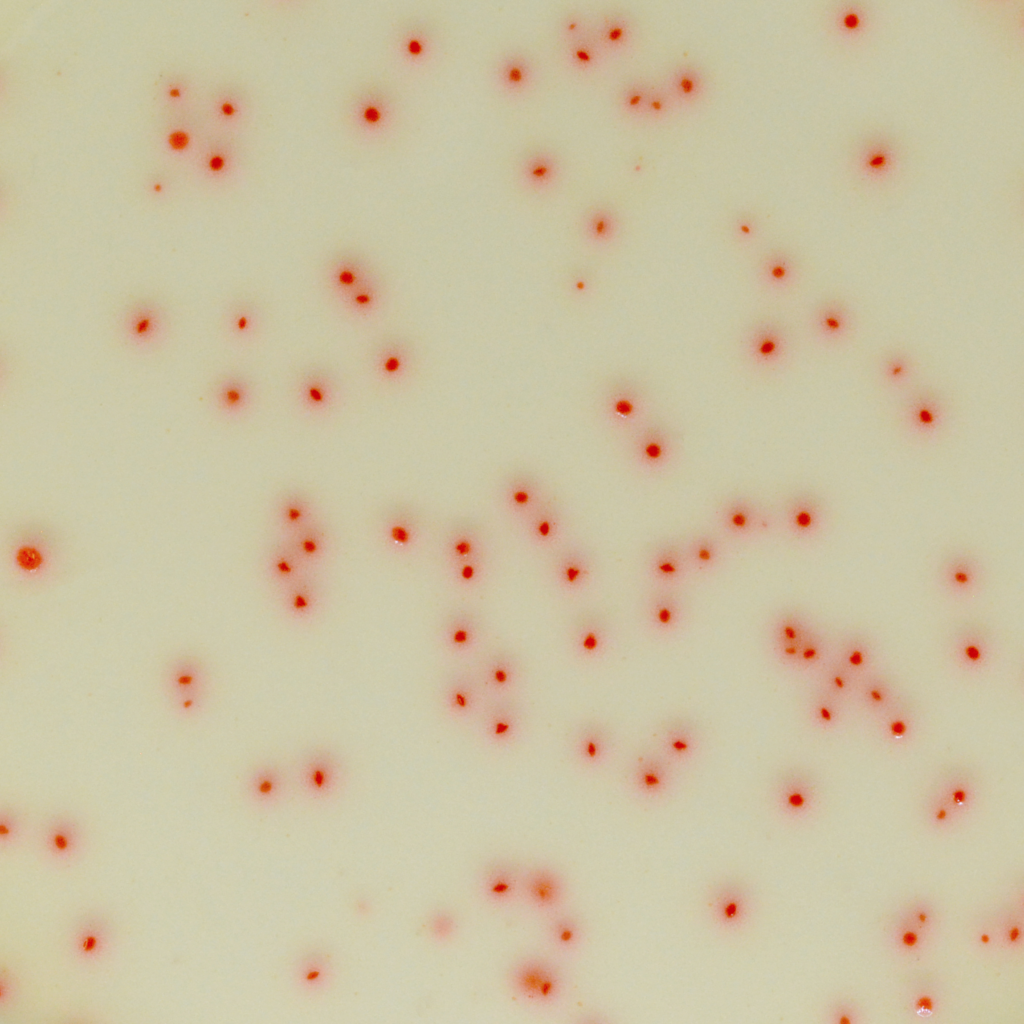
My Image 38

รายการ ภาพถ่ายเกี่ยวกับclostridium perfringens ใน อาหาร cleverlearn-hocthongminh.edu.vn clostridium perfringens ในอาหาร, clostridium perfringens em alimentos, clostridium perfringens in food, clostridium perfringens type a, clostridium perfringens typ a, clostridium perfringens alimentos envolvidos, clostridium perfringens o que é, clostridium perfringens en alimentos ซึ่งมีรายละเอียดเพิ่มเติมให้ดูที่ด้านล่างค่ะ
clostridium perfringens ใน อาหาร Cooked meat media with Clostridium perfringens. Tubes a & b showing 24 … Clostridium Perfringens Bacteria Photograph by Cnri/science Photo Library Clostridium Perfringens Bacterias: fotografía de stock © decade3d … Cooked meat media with Clostridium perfringens. Tubes a & b showing 24 … Base de Agar Clostridium Perfringens (m-CP) Formato 500 g Clostridium perfringens, a notorious pathogenic bacterium, isolated … Clostridium perfringens – scheda batteriologica ed approfondimenti Lecithinase activity of Clostridium perfringens in egg yolk agar … Gas Gangrene Bacteria, Sem Photograph by Biomedical Imaging Unit … Double zone of hemolysis produced by Clostridium perfringens on sheep … FSHN035/FS101: Preventing Foodborne Illness Associated with Clostridium … Clostridium perfringens on blood agar – a photo on Flickriver Cooked meat media with Clostridium perfringens. Tubes a & b showing 24 … Milk medium showing the classical stormy clot reaction of C … CHROMagar™ C. perfringens – Chromagar Pin on Microbiology clostridium perfringens | clostridium perfringens food poisoning … Uitbreiding van de indeling van Clostridium perfringens toxinotypes … A; C. perfringens culture on blood agar. B; TSC agar culture. C; TSC … Clostridium perfringens – Medien – Killah Potatoes Gaming Community Clostridium perfringens Selective Agar (SPS Agar): Scharlab.com … Clostridium Perfringens Bacteria by Cnri | Clostridium perfringens … Clostridium Perfringens Photographs | Fine Art America Perfringens TSC Agar, 55mm Plate – Southern Group Laboratory clostridium spp Clostridium spp | Microbiología, Bacteriologia, Microorganismos Enroque de ciencia: Clostridium perfringens Gram stained smear of pure culture of Clostridium perfringens showing … Scanning electron micrographs of C. perfringens CVCC61 treated with … Clostridium perfringens | Medical laboratory science, Medical … Coccus Bacteria – Clostridium Perfringens Foto d’archivio 156532337 … Clostridium Perfringens Round Beach Towel for Sale by Scimat Clostridium perfringens with spores – a photo on Flickriver Clostridium Difficile Bacteria Photograph by Science Photo Library Clostridium perfringens on Columbia Horse Blood Agar – a photo on … Clostridium sporogenes, spore forming, SEM – Stock Image – C032/2125 … Colonial morphology of Clostridium intestinale on brucella blood agar … CHROMagar™ C. perfringens – Chromagar GranuCult® Tryptose sulfite cycloserine agar (base) ISO 7937, ISO 14189 … Clostridium perfringens Selective Agar (SPS Agar): Scharlab.com … Clostridium Perfringens Round Beach Towel for Sale by Scimat Clostridium Perfringens Photograph by Dennis Kunkel Microscopy/science … 4 Clostridium perfringens enterotoxin ( CPE ) binds to claudins in the … Clostridium difficile bacteria, SEM – Stock Image – C004/3604 – Science … Pathology Outlines – Clostridioides difficile Clostridium Perfringens Type C & D – Tetanus Toxoid, 50 ml. Bottle Clostridium perfringens Clostridium Difficile Bacteria Photograph by Science Photo Library Clostridium Difficile Bacteria Photograph by Science Photo Library … Clostridium botulinum: características, morfologia, habitat … Toxigenic Clostridium difficile PCR | University of Washington … Clostridium Perfringens Ilustracje – Zdjęcia i ilustracje – iStock Clostridium Perfringens enterotossina causa diarrea cronica cane gatto … Clostridium Perfringens Bacteria Stock Photography | CartoonDealer.com … Clostridium perfringens Archives – Southern Group Laboratory C. perfringens on mCP agar | Download Scientific Diagram RKI – EM-Aufnahmen – Clostridium perfringens Milk medium showing the classical stormy clot reaction of three … Representation of the Clostridium perfringens Alpha toxin (CPA … Clostridium bacteria – Stock Image – B220/1694 – Science Photo Library Clostridium perfringens | bacteria | Britannica Clostridium – Clostridium difficile – Abioniv – The Reference in … Clostridium Perfringens Stock Photos, Pictures & Royalty-Free Images … Clostridium Bacteria Photograph by Biomedical Imaging Unit, Southampton … Gut flora infographics Cut Out Stock Images & Pictures – Alamy Lecithinase activity of Clostridium perfringens in egg yolk agar … Toxins | Free Full-Text | Clostridium perfringens Enterotoxin: Action … Pin on lab stuff Clostridium – Clostridium difficile – Abioniv – The Reference in … Clostridium difficile bacteria — Stock Photo © katerynakon #153501266 Thermo Scientific™ Oxoid™ Membrane Clostridium Perfringens Agar Base … Agar Clostridium Perfringens (sfp/tsc) – Frasco 500g | Kasvi – Botulab Animals | Free Full-Text | Clostridium perfringens as Foodborne … Epidemiological Studies on Clostridium Perfringens Food Poisoning: Buy … Clostridium septicum – Wikiwand د.كوثر pptx – العملي – Muhadharaty C. perfringens Prueba de CAMP reversa positiva | Laboratorio Nagler’s reaction (Lecithinase test) | Medical Laboratories Clostridium difficile Infection | Patient Information | JAMA | JAMA Network CLOSTRIDIUM PERFRINGENS AGAR BASE (Agar TSC), 500 g (ISO 7937-14189 … Clostridium perfringens (C. perfringens) is one of the most common … nanobugs® | Clostridium perfringens Clostridium Perfringens Bacterium Photograph by Cnri Clostridium difficile Toxins: The Nuts and Bolts – The Native Antigen … Bacteriological studies of C. perfringens isolate showing (a) rCMM with … Pathology Outlines – Clostridioides difficile Clostridium : Butolisme, Penyakit Saraf Mematikan Yang Disebabkan Oleh … Toxins of Clostridium perfringens | Veterian Key Clostridium Perfringens Bacterium Photograph by Cnri Adhesion assay of C. perfringens type A strain on HEp-2 cells. (A … Clostridium Perfringens Type C & D – Tetanus Toxoid, 20 ml. Bottle C. perfringens Delta toxin structure surface from the side (A) and from … Clostridium Difficile Agar (1005) – GRASO Biotech [PDF] Necrotic enteritis in chickens: an important disease caused by …